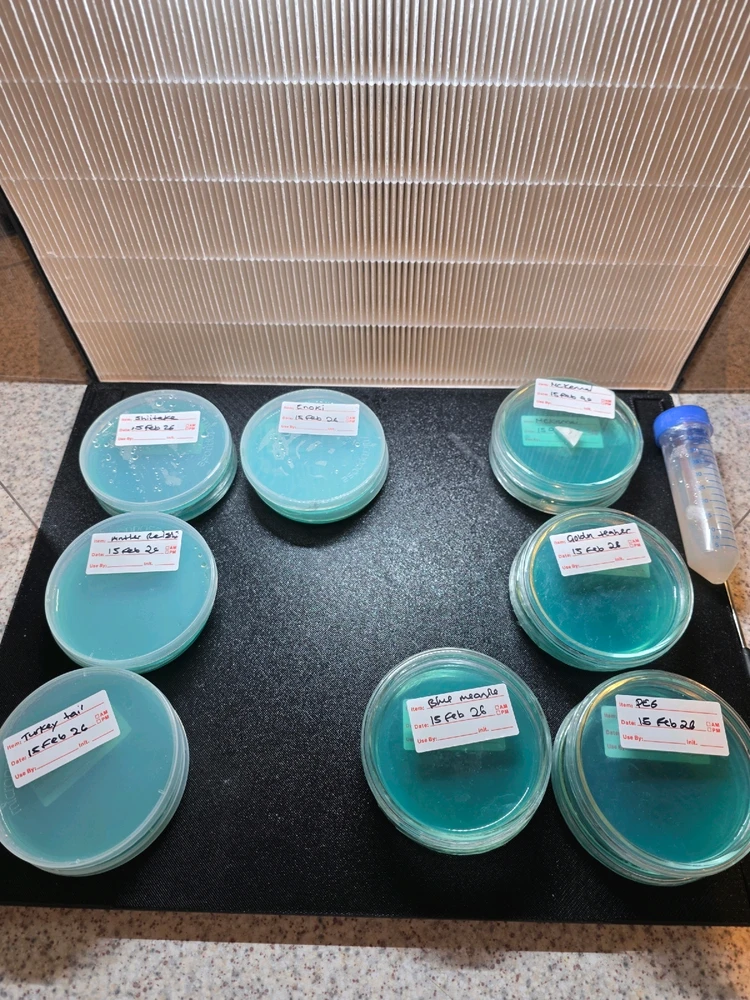
GIF diunggah dening Ash

Microscopy Community
The microscopy community, chat, and discussion.
83 jiwa
83 jiwa
5wulan
INTJ
Pises
Fungal Spores 800x magnification
Specifically *Lactifluus volemus var. flavus, aka: "fishy milkcap", and boy are they right. The smell was so strong, I smelled it before I located the fruitbodies themselves. They're a choice edible, but I wasn't 100% sure of identification until the spores were matched. Too late to eat them now.(besut)

5
0
5wulan
INTJ
Pises
Vorticella 800×
A small protozoan that feeds on bacteria. Note the stalk it uses to attach to substrate.


3
0
1wulan
INFJ
Wresaba
I want to take a sample of my phonescreen and put it on an agar plate, but I'm scared I'll never touch my phone again 😂
2
0
11wulan
ENFP
Leo
Lens crush </3
He did not deserve this.

1
1
6wulan
ENTJ
Cancer
Pyrocystis fusiformis
This is bioluminiscent algae from my bought culture at home. I also recorded timelapse of their chloroplast contraction to nucleus.



1
0
11wulan
ENFP
Leo
More tinies!
Dunno what this guy is, but I found a ton of them in a saltwater sample. They have a little pointy tail and cilla that seem to feed into it somewhere.

2
1
Ketemu Wong Anyar
50.000.000+ DOWNLOADS